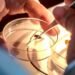
Campeche, bajo control sanitario por gusano barrenador

Por Karina Gómez
San Francisco de Campeche, Camp., a 09 de enero del 2026.- Dos equipos de la Copa Celta 2026 fueron expulsados luego del conato de riña que protagonizaron las porras de ambos en el encuentro de la Jornada 2 y que se volvió viral en redes sociales.
La Organización de la Copa Celta informó la decisión, luego de sostener una reunión la noche del jueves para analizar los hechos ocurridos durante la Jornada 2, en el partido de la categoría Sub-11 entre los equipos Lobos CFFAR y Cantera Cancún.
Ante dicha determinación y con apego al reglamento del torneo, ambos equipos se quedan sin la oportunidad de apelar la decisión.
Las imágenes de la pelea circularon en redes sociales, compartidas por padres de familia de equipos participantes, situación que generó preocupación entre la comunidad deportiva del torneo.

Ante este escenario, el comité organizador dejó en claro que no se tolerará ningún acto de violencia ni conductas que atenten contra el carácter formativo del certamen, el respeto entre los participantes y la sana convivencia que debe prevalecer en el fútbol infantil.
La Copa Celta reiteró que cualquier hecho similar será sancionado conforme a lo establecido en el reglamento, sin excepción, subrayando que el objetivo principal del torneo es la formación integral de niñas y niños dentro de un ambiente seguro, educativo y de juego limpio.
Asimismo, hizo un llamado directo y responsable a cuerpos técnicos, jugadores y familiares de todos los equipos participantes para respetar las normas y los valores que rigen la competencia, recordando que el comportamiento de los adultos también influye en la formación deportiva de los menores.
La organización fue enfática al señalar que este tipo de conductas no volverán a permitirse, reafirmando su compromiso con un torneo basado en el respeto, la disciplina y la sana convivencia.